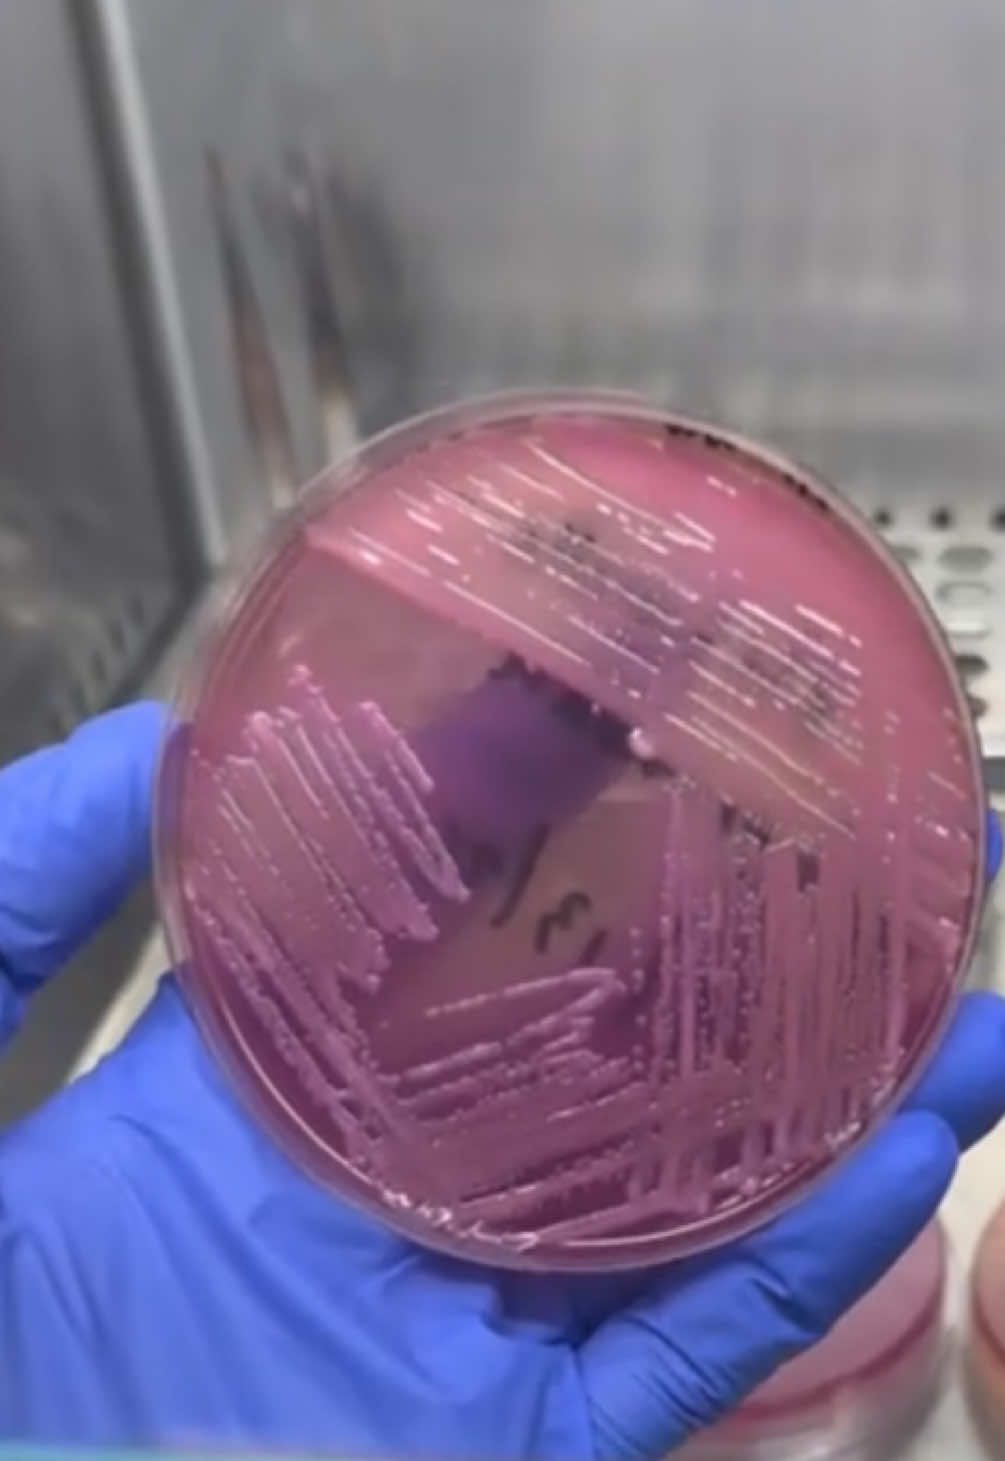

Mạnh con 12
Region: VN
Tuesday 21 October 2025 01:47:21 GMT
419
39
0
1
Music
Download
Comments
There are no more comments for this video.
To see more videos from user @mnh.vi.vn6, please go to the Tikwm
homepage.